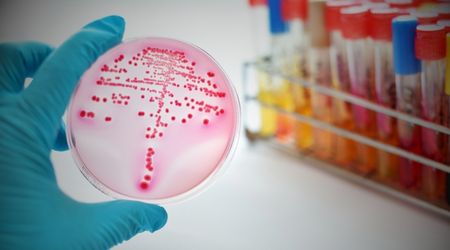

Gonore nedir? Bel soğukluğu nedir? Gonore (bel soğukluğu) belirtileri ve tedavisi nedir? Gonore (bel soğukluğu), cinsel yolla bulaşan bir enfeksiyondur.
Gonore (Bel Soğukluğu) Nedir?
Gonore nedir? Bel soğukluğu nedir? Halk arasında bel soğukluğu olarak da bilinir. Gonore, Neisseria gonorrhoeae bakterisinin neden olduğu, cinsel yolla bulaşan yaygın bir enfeksiyondur. Genital bölgeleri, rektumu ve boğazı etkileyebilir. Gonore, tedavi edilmediği takdirde kısırlık, pelvik inflamatuvar hastalık ve sistemik enfeksiyonlar gibi ciddi sorunlara neden olabilir.
Gonore Belirtileri Nelerdir?
Gonore belirtileri hem erkeklerde hem de kadınlarda görülebilir. Gonore bazen hiçbir belirti vermeyebilir ve bu nedenle farkında olmadan yayılmasına neden olabilir. Erkeklerde ve kadınlarda bazı farklı gonore belirtileri mevcuttur. Ancak ortak semptomlar da belirebilir.
Erkeklerde Gonore (Bel Soğukluğu) Belirtileri
- Penis ucundan beyaz/sarı akıntı
- İdrar yaparken ağrı ve yanma hissi
- Testislerde ağrı veya şişlik
Kadınlarda Gonore (Bel Soğukluğu) Belirtileri
- Anormal vajinal akıntı (sarı-yeşil)
- Vajinal kanama (adet dönemleri arasında veya cinsel ilişkiden sonra)
- Kasık ağrısı
Kadınlarda ve Erkeklerde Gonore (Bel Soğukluğu) Belirtileri
- Anal kaşıntı, kanama ve ağrı
- Boğaz enfeksiyonları
- Göz enfeksiyonları

Gonore Nasıl Teşhis Edilir?
Gonore (bel soğukluğu), belirtileriniz varsa uzman bir hekime başvurmalısınız. Doktorunuz, belirtiler ve cinsel geçmişiniz hakkında sorular sorar. Daha sonra bel soğukluğuna neden olan bakterileri kontrol etmek için idrarınızdan veya vücut sıvınızdan örnek toplar. Hangi testin gerekli olduğuna uzman hekim karar verir.
- Pelvik muayene yapılır ve test için servikten sıvı örneği alınır.
- İdrar örneği alınır.
- Boğazdan veya rektumdan sıvı alınır.
- Penisten sıvı örneği alınır.
Gonore Nasıl Tedavi Edilir?
Gonore tedavisi, klasik tıpta genellikle antibiyotik birincil yöntem olarak kullanılır. Aynı şekilde partnerinizin de antibiyotik tedavisi olması gerekir. Bu yöntemle genelde başarılı sonuçlar elde edilse de son dönemlerde antibiyotik ile tedavilerde bazı dirençli bakteriler nedeniyle sonuç alamama riski söz konusudur. Bu durumda bağışıklık sisteminin güçlü olması önem taşır. Fonksiyonel tıpta hedef, bağışıklık direncini artırmak ve detoksifikasyon yollarını açarak vücudu enfeksiyona karşı güçlendirmektir.
Bütüncül Tıp Yaklaşımında Gonore (Bel Soğukluğu) Tedavisi
Bütüncül tıp ile cinsel hastalıkların etkilerini azaltmak, hastalıktan kurtulmak ve de hastalığa yakalanma riskini düşürmek mümkündür. Bakteriyel bulaş hastalıkların direncini kırmanın birincil yolu güçlü bağışıklıktır. Tüm tedavi protokollerinde hızlı sonuç almanın yegane koşulu da budur. Cinsel hastalık ile ilgili şüphe durumlarında bütüncül tıp uzmanına başvurmanız önem taşımaktadır.
Gonore (bel soğukluğu) tedavisinde bütüncül tıp yaklaşımı, destekleyici ve tamamlayıcı yöntemler sunar. Antibiyotik tedavisine ek olarak, fonksiyonel tıp yaklaşımları vücudun genel sağlığını ve bağışıklık sistemini destekleyerek iyileşme sürecini hızlandırmaya ve komplikasyon riskini azaltmaya yardımcı olabilir.
Gonore (Bel Soğukluğu) ve Biorezonans
- Biorezonans (elektrikli akupunktur), vücudun enerji alanlarını dengeleyerek ve hücresel iletişimi optimize ederek bağışıklık sistemini güçlendirmeyi amaçlar.
- Enfeksiyona neden olan Neisseria gonorrhoeae bakterisine özgü frekanslar tespit edilir.
- Vücuda hastalık frekansına karşı düzenleyici frekanslar gönderilir.
- Vücudun bakterilere karşı direncini artırarak ve detoksifikasyon süreçlerini destekleyerek enfeksiyonlarla mücadelede yardımcı olur.
Gonore (Bel Soğukluğu) ve Hacamat
- Hacamat (Kupa tedavisi), kan ve lenf dolaşımını hızlandırarak detoks sürecini destekler.
- Pelvik bölgeye yakın noktalara uygulandığında bölgesel inflamasyonu azaltabilir.
- Vücutta biriken toksinlerin uzaklaştırılmasına yardımcı olur.
- Yorgunluk ve bağışıklık düşüklüğü gibi sistemik etkileri hafifletebilir.
- Tedavi sürecine bütünsel denge sağlar.
Gonore (Bel Soğukluğu) ve Ozon Tedavisi
- Ozon tedavisi, bağışıklık sistemini uyararak Neisseria gonorrhoeae gibi bakterilerle mücadelede vücuda destek olabilir.
- Ozon gazı, doğal antibakteriyel etkiye sahiptir.
- Oksijenlenmeyi artırarak dokuların iyileşmesini hızlandırır.
- Bağışıklık hücrelerini aktive eder.
- Nöralterapi: Antiviral tedaviye destek sağlar.
Gonore (Bel Soğukluğu) hastalığı hakkında bütüncül yaklaşım protokolleri ile ilgili daha fazla bilgi almak ve ücretsiz ön görüşme için iletişime geçebilirsiniz.






